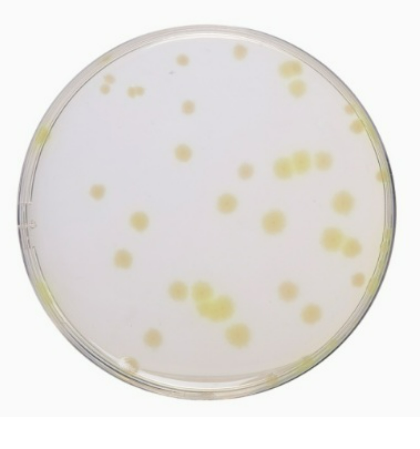
Related Product - 4071
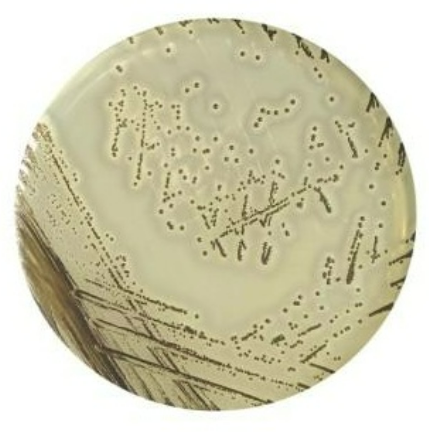
Related Product - 4064
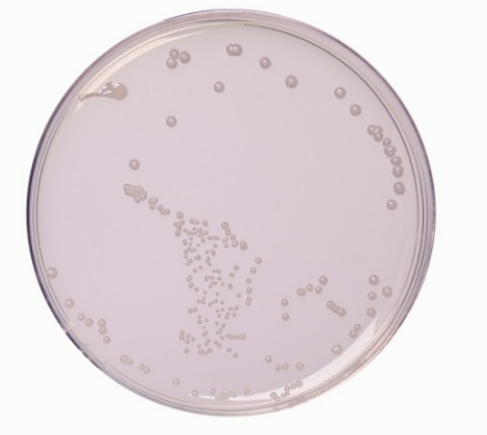
Related Product - 4062
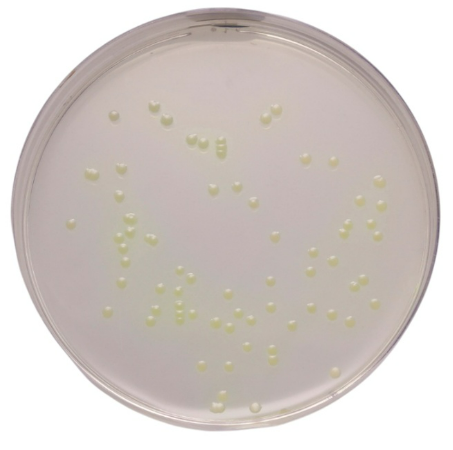
Related Product - 4057

Ausmedia Peptone Water, in 120 ml Jar, 50 jars/pack
$247.50 inc-GST
Ausmedia Peptone Water, in 120 ml Jar, 50 jars/pack
Quantity:
Ausmedia Peptone Water is one of the simplest and most versatile non-selective broth media used in microbiology. It primarily consists of peptic digest of animal tissue (peptone) and sodium chloride.
Key Functions and Uses
Peptone water serves three main roles in laboratory settings:
• Biochemical Differentiation: It is the standard base for the Indole Test because the peptone used is rich in tryptophan. A red ring forms at the surface after adding Kovac’s reagent if indole is produced.
• Carbohydrate Fermentation: It acts as a basal medium to which specific sugars and pH indicators (like phenol red) are added to study an organism's fermentation patterns.
• Diluent and Enrichment: It is used as a Maximum Recovery Diluent (MRD) to maintain bacterial viability during serial dilutions without promoting excessive growth.

Customer Reviews